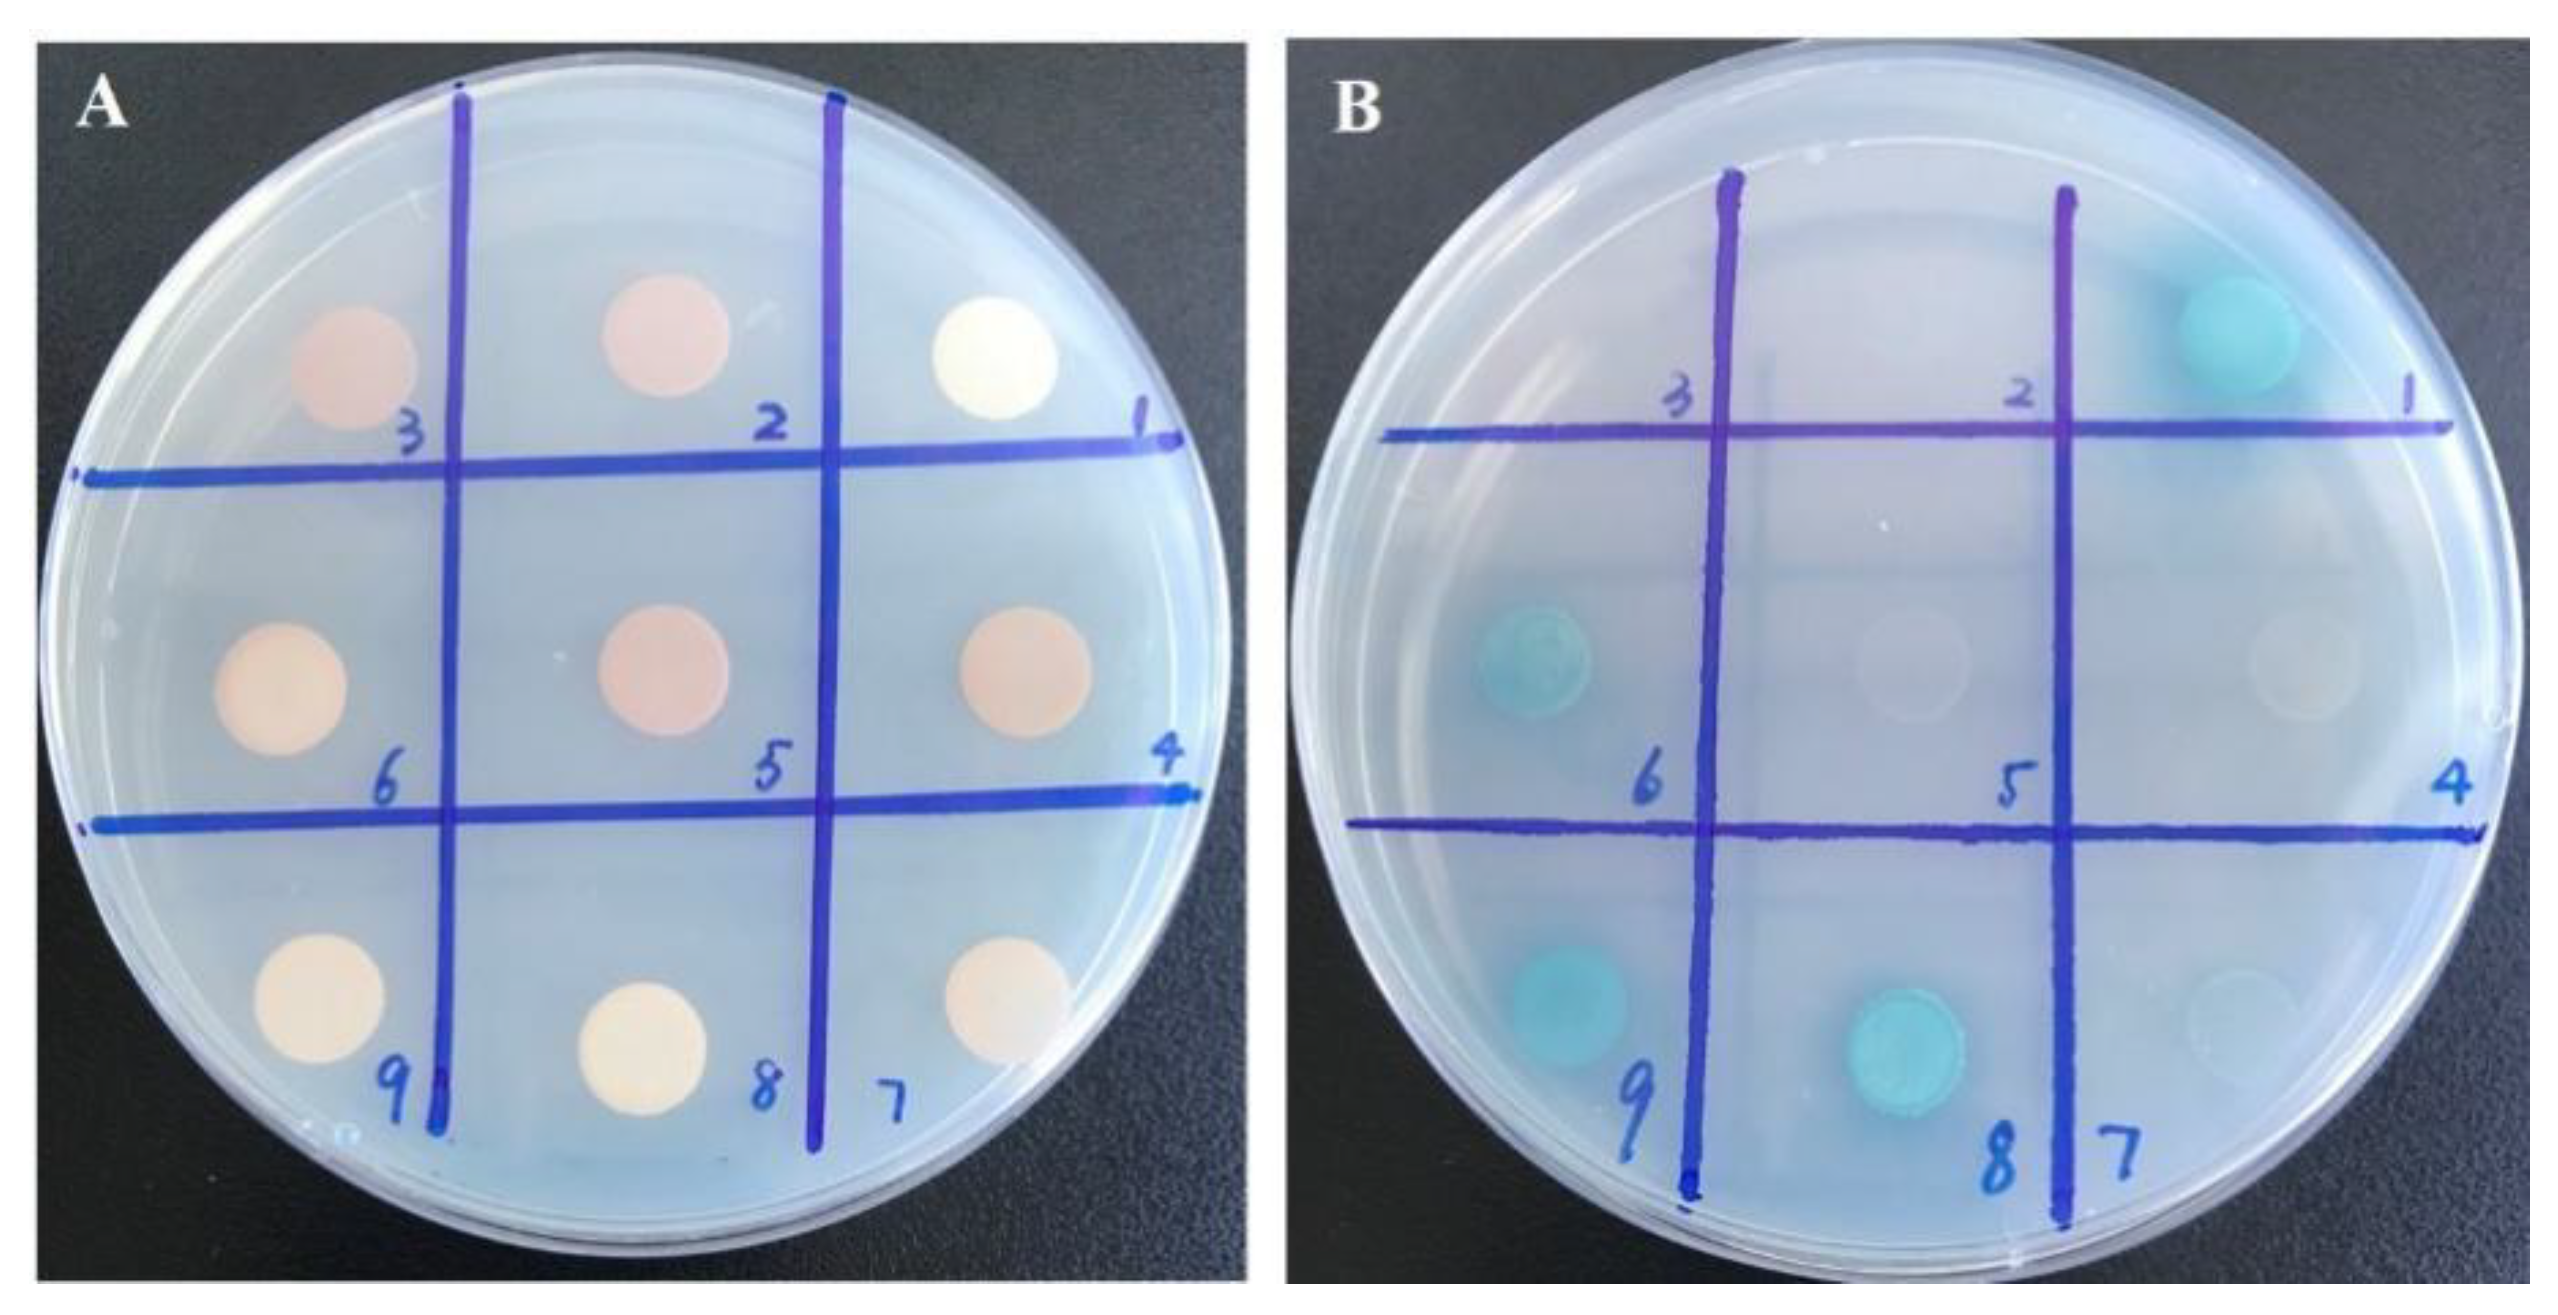
Ijms 22 09344 g004

Expression Analysis of MaTGA8 Transcription Factor in Banana and Its Defence Functional Analysis by Overexpression in Arabidopsis
Abstract
1. Introduction
2. Results
2.1. Analysis of MaTGA8 Gene
2.2. Promoter Analysis for Detection of Putative Cis-Elements
2.3. Expression Level of MaTGA8 and MaNPR1 under Stress Treatments
2.4. Yeast Two-Hybrid Assays
2.5. Sub-Cellular Localization of MusaTGA8
2.6. Overexpression of MaTGA8 Increase Foc TR4 Resistance in Arabidopsis
3. Discussion
4. Materials and Methods
4.1. Plant Materials and Growth Conditions
4.2. Bacterial Strains
4.3. The Total RNA Extraction and Quantitative Real-Time PCR (qRT-PCR)
4.4. Cloning and Sequence Analysis of MaTGA8
4.5. Plastid Construction and Generation of Transgenic Arabidopsis Plants
4.6. Subcellular Localization of MaTGA8
4.7. Yeast Two-Hybrid Assays
4.8. Foc TR4 Treatment in Transgenic Arabidopsis
4.9. Statistical Analysis
5. Conclusions
Supplementary Materials
Author Contributions
Funding
Institutional Review Board Statement
Informed Consent Statement
Data Availability Statement
Conflicts of Interest
References
- Butterbrodt, T.; Thurow, C.; Gatz, C. Chromatin immunoprecipitation analysis of the tobacco PR-1a-and the truncated CaMV 35S promoter reveals differences in salicylic acid-dependent TGA factor binding and histone acetylation. Plant Mol. Biol. 2006, 61, 665–674. [Google Scholar] [CrossRef] [PubMed]
- Gatz, C. From Pioneers to Team Players: TGA Transcription Factors Provide a Molecular Link between Different Stress Pathways. Mol. Plant Microbe Interact. 2013, 26, 151–159. [Google Scholar] [CrossRef] [PubMed]
- Zhang, Y.; Tessaro, M.J.; Lassner, M.; Li, X. Knockout Analysis of Arabidopsis Transcription Factors TGA2, TGA5, and TGA6 Reveals Their Redundant and Essential Roles in Systemic Acquired Resistance. Plant Cell 2003, 15, 2647–2653. [Google Scholar] [CrossRef] [PubMed]
- Zander, M.; La Camera, S.; LaMotte, O.; Métraux, J.-P.; Gatz, C. Arabidopsis thaliana class-II TGA transcription factors are essential activators of jasmonic acid/ethylene-induced defense responses. Plant J. 2009, 61, 200–210. [Google Scholar] [CrossRef] [PubMed]
- Sun, T.; Busta, L.; Zhang, Q.; Ding, P.; Jetter, R.; Zhang, Y. TGACG-BINDING FACTOR 1 (TGA1) and TGA4 regulate salicylic acid and pipecolic acid biosynthesis by modulating the expression of SYSTEMIC ACQUIRED RESISTANCE DEFICIENT 1 (SARD1) and CALMODULIN-BINDING PROTEIN 60g (CBP60g). New Phytol. 2018, 217, 344–354. [Google Scholar] [CrossRef] [PubMed]
- Hepworth, S.; Zhang, Y.; McKim, S.; Li, X.; Haughn, G.W. BLADE-ON-PETIOLE–Dependent Signaling Controls Leaf and Floral Patterning in Arabidopsis. Plant Cell 2005, 17, 1434–1448. [Google Scholar] [CrossRef]
- Xu, M.; Hu, T.; McKim, S.M.; Murmu, J.; Haughn, G.W.; Hepworth, S.R. Arabidopsis BLADE-ON-PETIOLE1 and 2 promote floral meristem fate and determinacy in a previously undefined pathway targeting APETALA1 and AGAMOUS-LIKE24. Plant J. 2010, 63, 974–989. [Google Scholar] [CrossRef]
- Maier, A.T.; Stehling-Sun, S.; Offenburger, S.-L.; Lohmann, J.U. The bZIP Transcription Factor PERIANTHIA: A Multifunctional Hub for Meristem Control. Front. Plant Sci. 2011, 2, 79. [Google Scholar] [CrossRef]
- Espín, F.M.I.; Peraza-Echeverria, S.; Fuentes, G.; Santamaría, J.M. In silico cloning and characterization of the TGA (TGACG MOTIF-BINDING FACTOR) transcription factors subfamily in Carica papaya. Plant Physiol. Biochem. 2012, 54, 113–122. [Google Scholar] [CrossRef]
- Moon, S.-J.; Park, H.J.; Kim, T.-H.; Kang, J.-W.; Lee, J.-Y.; Cho, J.-H.; Lee, J.-H.; Park, D.-S.; Byun, M.-O.; Kim, B.-G.; et al. OsTGA2 confers disease resistance to rice against leaf blight by regulating expression levels of disease related genes via interaction with NH1. PLoS ONE 2018, 13, e0206910. [Google Scholar] [CrossRef]
- Ullah, I.; Magdy, M.; Wang, L.; Liu, M.; Li, X. Genome-wide identification and evolutionary analysis of TGA transcription factors in soybean. Sci. Rep. 2019, 9, 1–14. [Google Scholar] [CrossRef] [PubMed]
- Feng, J.; Cheng, Y.; Zheng, C. Expression patterns of octoploid strawberry TGA genes reveal a potential role in response to Podosphaera aphanis infection. Plant Biotechnol. Rep. 2019, 14, 55–67. [Google Scholar] [CrossRef]
- Behringer, C.; Bartsch, K.; Schaller, A. Safeners recruit multiple signalling pathways for the orchestrated induction of the cellular xenobiotic detoxification machinery in Arabidopsis. Plant Cell Environ. 2011, 34, 1970–1985. [Google Scholar] [CrossRef] [PubMed]
- Du, X.; Du, B.; Chen, X.; Zhang, S.; Zhang, Z.; Qu, S. Overexpression of the MhTGA2 gene from crab apple (Malus hupehensis) confers increased tolerance to salt stress in transgenic apple (Malus domestica). J. Agric. Sci. 2013, 152, 634–641. [Google Scholar] [CrossRef]
- Alvarez, J.M.; Riveras, E.; Vidal, E.A.; Gras, D.E.; Contreras-López, O.; Tamayo, K.P.; Aceituno, F.; Gómez, I.; Ruffel, S.; Lejay, L.; et al. Systems approach identifies TGA1 and TGA4 transcription factors as important regulatory components of the nitrate response of Arabidopsis thaliana roots. Plant J. 2014, 80, 1–13. [Google Scholar] [CrossRef] [PubMed]
- Canales, J.; Contreras-López, O.; Álvarez, J.M.; Gutiérrez, R.A. Nitrate induction of root hair density is mediated by TGA1/TGA4 and CPC transcription factors in Arabidopsis thaliana. Plant J. 2017, 92, 305–316. [Google Scholar] [CrossRef]
- Li, B.; Liu, Y.; Cui, X.Y.; Fu, J.D.; Zhou, Y.B.; Zheng, W.J.; Lan, J.H.; Jin, L.G.; Chen, M.; Ma, Y.Z. Genome-Wide characterization and expression analysis of soybean TGA transcription factors identified a novel TGA gene involved in drought and salt tolerance. Front. Plant Sci. 2019, 10, 549. [Google Scholar] [CrossRef]
- Fu, Z.Q.; Dong, X. Systemic Acquired Resistance: Turning Local Infection into Global Defense. Annu. Rev. Plant Biol. 2013, 64, 839–863. [Google Scholar] [CrossRef]
- Wither, J.; Dong, X. Posttranslational modifications of NPR1: A single protein playing multiple roles in plant immunity and physiology. PLoS Pathog. 2016, 12, e1005707. [Google Scholar] [CrossRef]
- Fitzgerald, H.A.; Canlas, P.E.; Chern, M.-S.; Ronald, P.C. Alteration of TGA factor activity in rice results in enhanced tolerance to Xanthomonas oryzae pv. oryzae. Plant J. 2005, 43, 335–347. [Google Scholar] [CrossRef]
- Van Verk, M.C.; Neeleman, L.; Bol, J.F.; Linthorst, H.J.M. Tobacco Transcription Factor NtWRKY12 Interacts with TGA2.2 in vitro and in vivo. Front. Plant Sci. 2011, 2, 32. [Google Scholar] [CrossRef]
- Zander, M.; Thurow, C.; Gatz, C. TGA transcription factors activate the salicylic acid-suppressible branch of the ethylene-induced defense program by regulating ORA59 expression. Plant Physiol. 2014, 165, 1671–1683. [Google Scholar] [CrossRef] [PubMed]
- Choi, J.; Huh, S.U.; Kojima, M.; Sakakibara, H.; Paek, K.-H.; Hwang, I. The Cytokinin-Activated Transcription Factor ARR2 Promotes Plant Immunity via TGA3/NPR1-Dependent Salicylic Acid Signaling in Arabidopsis. Dev. Cell 2010, 19, 284–295. [Google Scholar] [CrossRef] [PubMed]
- Endah, R.; Beyene, G.; Kiggundu, A.; Berg, N.V.D.; Schlüter, U.; Kunert, K.; Chikwamba, R. Elicitor and Fusarium-induced expression of NPR1-like genes in banana. Plant Physiol. Biochem. 2008, 46, 1007–1014. [Google Scholar] [CrossRef] [PubMed]
- Wang, Z.; Jia, C.; Li, J.; Huang, S.; Xu, B.; Jin, Z. Activation of salicylic acid metabolism and signal transduction can enhance resistance to Fusarium wilt in banana (Musa acuminata L. AAA group, cv. Cavendish). Funct. Integr. Genom. 2014, 15, 47–62. [Google Scholar] [CrossRef] [PubMed]
- Sun, J.; Zhang, J.; Fang, H.; Peng, L.; Wei, S.; Li, C.; Zheng, S.; Lu, J. Comparative transcriptome analysis reveals resistance-related genes and pathways in Musa acuminata banana ’Guijiao 9’ in response to Fusarium wilt. Plant Physiol. Biochem. 2019, 141, 83–94. [Google Scholar] [CrossRef]
- Pieterse, C.M.; van der Does, D.; Zamioudis, C.; Leon-Reyes, A.; Van Wees, S. Hormonal modulation of plant immunity. Annu. Rev. Cell Dev. Biol. 2012, 28, 489–521. [Google Scholar] [CrossRef]
- Bai, T.-T.; Xie, W.-B.; Zhou, P.-P.; Wu, Z.-L.; Xiao, W.-C.; Zhou, L.; Sun, J.; Ruan, X.-L.; Li, H.-P. Transcriptome and Expression Profile Analysis of Highly Resistant and Susceptible Banana Roots Challenged with Fusarium oxysporum f. sp. cubense Tropical Race 4. PLoS ONE 2013, 8, e73945. [Google Scholar] [CrossRef]
- Li, W.; Li, C.; Sun, J.; Peng, M. Metabolomic, Biochemical, and Gene Expression Analyses Reveal the Underlying Responses of Resistant and Susceptible Banana Species during Early Infection with Fusarium oxysporum f. sp. cubense. Plant Dis. 2017, 101, 534–543. [Google Scholar] [CrossRef]
- Dita, M.; Barquero, M.; Heck, D.W.; Mizubuti, E.S.G.; Staver, C.P. Fusarium Wilt of Banana: Current Knowledge on Epidemiology and Research Needs Toward Sustainable Disease Management. Front. Plant Sci. 2018, 9, 1468. [Google Scholar] [CrossRef] [PubMed]
- Olivares, B.O.; Araya-Alman, M.; Acevedo-Opazo, C.; Rey, J.C.; Cañete-Salinas, P.; Kurina, F.G.; Balzarini, M.; Lobo, D.; Navas-Cortés, J.A.; Landa, B.B.; et al. Relationship between Soil Properties and Banana Productivity in the Two Main Cultivation Areas in Venezuela. J. Soil Sci. Plant Nutr. 2020, 20, 2512–2524. [Google Scholar] [CrossRef]
- Dröge-Laser, W.; Snoek, B.L.; Snel, B.; Weiste, C. The Arabidopsis bZIP transcription factor family—An update. Curr. Opin. Plant Biol. 2018, 45, 36–49. [Google Scholar] [CrossRef]
- Hu, W.; Wang, L.; Tie, W.; Yan, Y.; Ding, Z.; Liu, J.; Li, M.; Peng, M.; Xu, B.; Jin, Z. Genome-wide analyses of the bZIP family reveal their involvement in the development, ripening and abiotic stress response in banana. Sci. Rep. 2016, 6, 30203. [Google Scholar] [CrossRef] [PubMed]
- Miyamoto, K.; Nishizawa, Y.; Minami, E.; Nojiri, H.; Yamane, H.; Okada, K. Overexpression of the bZIP transcription factor OsbZIP79 suppresses the production of diterpenoid phytoalexin in rice cells. J. Plant Physiol. 2014, 173, 19–27. [Google Scholar] [CrossRef]
- Cheng, M.-C.; Liao, P.-M.; Kuo, W.-W.; Lin, T.-P. The Arabidopsis ETHYLENE RESPONSE FACTOR1 Regulates Abiotic Stress-Responsive Gene Expression by Binding to Different cis-Acting Elements in Response to Different Stress Signals. Plant Physiol. 2013, 162, 1566–1582. [Google Scholar] [CrossRef] [PubMed]
- Mou, Z.; Fan, W.; Dong, X. Inducers of Plant Systemic Acquired Resistance Regulate NPR1 Function through Redox Changes. Cell 2003, 113, 935–944. [Google Scholar] [CrossRef]
- Després, C.; Chubak, C.; Rochon, A.; Clark, R.; Bethune, T.; Desveaux, D.; Fobert, P.R. The Arabidopsis NPR1 disease resistance protein is a novel cofactor that confers redox regulation of DNA binding activity to the basic domain/leucine zipper transcription factor TGA1. Plant Cell 2003, 15, 2181–2191. [Google Scholar] [CrossRef] [PubMed]
- Zhang, Y.; Fan, W.; Kinkema, M.; Li, X.; Dong, X. Interaction of NPR1 with basic leucine zipper protein transcription factors that bind sequences required for salicylic acid induction of the PR-1 gene. Proc. Natl. Acad. Sci. USA 1999, 96, 6523–6528. [Google Scholar] [CrossRef]
- Lindermayr, C.; Sell, S.; Müller, B.; Leister, D.; Durner, J. Redox Regulation of the NPR1-TGA1 System of Arabidopsis thaliana by Nitric Oxide. Plant Cell 2010, 22, 2894–2907. [Google Scholar] [CrossRef] [PubMed]
- Stotz, H.U.; Findling, S.; Nukarinen, E.; Weckwerth, W.; Mueller, M.J.; Berger, S. A tandem affinity purification tag of TGA2 for isolation of interacting proteins in Arabidopsis thaliana. Plant Signal. Behav. 2014, 9, e972794. [Google Scholar] [CrossRef][Green Version]
- Xiao, S.; Chye, M.-L. Overexpression of Arabidopsis ACBP3 Enhances NPR1-Dependent Plant Resistance to Pseudomonas syringe pv tomato DC3000. Plant Physiol. 2011, 156, 2069–2081. [Google Scholar] [CrossRef] [PubMed]
- Wang, K.; Li, C.; Lei, C.; Jiang, Y.; Qiu, L.; Zou, X.; Zheng, Y. β-aminobutyric acid induces priming defence against Botrytis cinerea in grapefruit by reducing intercellular redox status that modifies posttranslation of VvNPR1 and its interaction with VvTGA1. Plant Physiol. Biochem. 2020, 156, 552–565. [Google Scholar] [CrossRef] [PubMed]
- Xiang, C.; Miao, Z.; Lam, E. DNA-binding properties, genomic organization and expression pattern of TGA6, a new member of the TGA family of bZIP transcription factors in Arabidopsis thaliana. Plant Mol. Biol. 1997, 34, 403–415. [Google Scholar] [CrossRef] [PubMed]
- Fode, B.; Siemsen, T.; Thurow, C.; Weigel, R.; Gatz, C. The Arabidopsis GRAS protein SCL14 interacts with class II TGA transcription factors and is essential for the activation of stress-inducible promoters. Plant Cell 2008, 20, 3122–3135. [Google Scholar] [CrossRef]
- Olivares, B.; Rey, J.; Lobo, D.; Navas-Cortés, J.; Gómez, J.; Landa, B. Fusarium Wilt of Bananas: A Review of Agro-Environmental Factors in the Venezuelan Production System Affecting Its Development. Agronomy 2021, 11, 986. [Google Scholar] [CrossRef]
- Olivares Campos, B.; Paredes, F.; Rey, J.; Lobo, D.; Galvis-Causil, S. The relationship between the normalized difference vegetation index, rainfall, and potential evapotranspiration in a banana plantation of Venezuela. Sains Tanah J. Soil Sci. Agroclimatol. 2021, 18, 58–64. [Google Scholar] [CrossRef]
- Narusaka, M.; Shiraishi, T.; Iwabuchi, M.; Narusaka, Y. The floral inoculating protocol: A simplified Arabidopsis thaliana transformation method modified from floral dipping. Plant Biotechnol. 2010, 27, 349–351. [Google Scholar] [CrossRef]

| Motif | Function |
|---|---|
| MRE | Light-response element |
| TCCC-motif | Light-response element |
| TCT-motif | Light-response element |
| G-box | Light-response element |
| GATA-motif | Light-response element |
| GT1-motif | Light-response element |
| CAT-box | Meristem expression |
| TCA-element | Involved in SA responsiveness |
| TGACG-motif | MeJA response element |
| CGTCA-motif | MeJA response elements |
| GARE-motif | Gibberellin response element |
| P-box | Gibberellin response element |
| ABRE | Abscisic acid reactive cis-acting element |
| MBS | MYB binding site involved in drought-inducibility |
| RY-element | Seed-specific regulation |
Publisher’s Note: MDPI stays neutral with regard to jurisdictional claims in published maps and institutional affiliations. |
© 2021 by the authors. Licensee MDPI, Basel, Switzerland. This article is an open access article distributed under the terms and conditions of the Creative Commons Attribution (CC BY) license (https://creativecommons.org/licenses/by/4.0/).
Share and Cite
Lin, P.; Dong, T.; Chen, W.; Zou, N.; Chen, Y.; Li, Y.; Chen, K.; Wang, M.; Liu, J. Expression Analysis of MaTGA8 Transcription Factor in Banana and Its Defence Functional Analysis by Overexpression in Arabidopsis. Int. J. Mol. Sci. 2021, 22, 9344. https://doi.org/10.3390/ijms22179344
Lin P, Dong T, Chen W, Zou N, Chen Y, Li Y, Chen K, Wang M, Liu J. Expression Analysis of MaTGA8 Transcription Factor in Banana and Its Defence Functional Analysis by Overexpression in Arabidopsis. International Journal of Molecular Sciences. 2021; 22(17):9344. https://doi.org/10.3390/ijms22179344
Chicago/Turabian StyleLin, Ping, Tao Dong, Wenliang Chen, Niexia Zou, Yinglong Chen, Yuqing Li, Kelin Chen, Mingyuan Wang, and Jianfu Liu. 2021. "Expression Analysis of MaTGA8 Transcription Factor in Banana and Its Defence Functional Analysis by Overexpression in Arabidopsis" International Journal of Molecular Sciences 22, no. 17: 9344. https://doi.org/10.3390/ijms22179344
APA StyleLin, P., Dong, T., Chen, W., Zou, N., Chen, Y., Li, Y., Chen, K., Wang, M., & Liu, J. (2021). Expression Analysis of MaTGA8 Transcription Factor in Banana and Its Defence Functional Analysis by Overexpression in Arabidopsis. International Journal of Molecular Sciences, 22(17), 9344. https://doi.org/10.3390/ijms22179344

